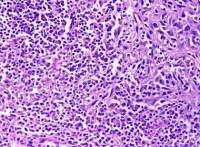
MEF;小鼠胚胎成纤维细胞

相关产品推荐更多 >
万千商家帮你免费找货
0 人在求购买到急需产品
- 详细信息
- 技术资料
- 库存:
100
- 细胞类型:
科研
- 品系:
详情请咨询我司客服
- 组织来源:
详情请咨询我司客服
- 物种来源:
鼠/人/其它
- 细胞形态:
上皮样/成纤维样/其它
- 器官来源:
详情请咨询我司客服
- 运输方式:
常温运输/干冰运输
- 年限:
详情请咨询我司客服
- 生长状态:
贴壁/悬浮
- 英文名:
HBL-100
产品介绍:
HBL-100;乳腺细胞主要来源ATCC、ScienCell、DSMZ、以及少数国内外著名大学建系
产品优势:
烜雅生物公司提供贴壁、半贴壁、悬浮、半悬浮、贴壁与悬浮混合等细胞特性,一般细胞培养PBS量是10%,如果出现细胞状态不良情况,可以提高PBS量到15%,待细胞稳定后,调回PBS量10%,对于初次实验者,一般细胞培养,都需要加入双抗防止细胞污染,细胞汇合度达到90%,我们开始寄送
细胞培养简介:
什么是细胞培养?细胞培养是从动物或植物中取出细胞,然后使其在合适的人工环境中生长。这些细胞可于培养前直接从组织中取出并采用酶或机械方法进行解离,或者也可来自已经建立的细胞系或细胞株。
1)原代培养:
原代培养是指将细胞从组织中分离后,使其在合适的条件下增值直到占据所有可用基质(即:达到汇合状态)的培养阶段。在此阶段。必须将细胞转移到新的容器中并更换新鲜培养基,从而对细胞进行传代培养,为其提供更多继续生长的空间。
2)细胞系:
首次传代培养后,原代培养物即被称为细胞系或者亚克隆。来自于原代培养的细胞系寿命有限(即:有限细胞系,见下文),随细胞的传代,生长能力最强的细胞会占据优势,最终导致细胞群体在基因型和表型上达到一定程度的均一性。
3)细胞株:
如果将细胞系的一个亚群通过克隆或者其他方法从培养物中明确地选择出来,则次细胞系就成为一个细胞株。与亲代细胞系起始时相比,细胞株往往会获得其他一些遗传学改变。
HBL-100;乳腺细胞培养基的选择和使用:
MEM:成分简单,推荐贴壁细胞使用。
DMEM:分高糖型和低糖型。
IDMEM:适合细胞密度低,生长困难的细胞。如杂交细胞的筛选,DNA转染后转化细胞的筛选培养。
RPM1640:应用最广泛的培养基之一。推荐悬浮细胞培养使用,主要针对淋巴细胞,也适合其他细胞。
199、109培养基:成分齐全,培养效果较好。
F10培养基:适合小鼠及人类二倍体细胞培养。
F12培养基:适合单细胞分离培养及无血清培养。
McCoy’s5A培养基:特别适合原代细胞及较难培养细胞的生长。"95%(Viability by Trypan Blue Exclusion)
产品图片:
【细胞检测】:细胞不含有HIV-1、HBV、HCV、支原体、细菌、酵母和真菌
【培养条件】:详见细胞说明书
【传代方法】:建议1:2-1:3 两天换液一次
【冻存条件】:详见细胞说明书
【主要文献】:请具体查阅相关发表文章
造成实验室细胞污染常见情况总结:
细胞培养中最常见污染的是细菌、真菌和支原体污染。细胞一旦污染,大多数较难处理。那么,哪些情况我们不注意的话就会造成细胞污染呢?我们根据常见细胞培养实验分析总结下。
违规操作:1. 为节省时间,有人已经用超净台四个多小时,不开紫外灭菌30min,酒精擦拭后直接开始试验。2. 器材或者溶液很久没用,未检测是否污染而直接使用;离心管多次使用,枪头为了方便交叉使用。3. 超净台不点酒精灯;点了酒精灯放在右上角,而你在左下角做试验。4. 不带手套,徒手操作。5. 细胞培养间配备枪式移液器、手术器械、离心机、冰箱等专用仪器设备以及专用的实验服和拖鞋,未定期消毒。
HBL-100;乳腺细胞专用物品被带出细胞房使用。培养细胞过程中使用的所有实验用具,如移液管、一次性枪头、一次性塑料离心管、冻存管等未按要求灭菌使用(通常需121°C高压灭菌20分钟后37%烤干备用)。
1,超净台和桌面,东西太多太乱
2,箱太久没清洁
3,细胞房人多口杂,难管理:
希望这些培养的方法可以帮到您
HBL-100;乳腺细胞(相关产品):
HBL-100;乳腺细胞主要来源ATCC、ScienCell、DSMZ、以及少数国内外著名大学建系
产品优势:
烜雅生物公司提供贴壁、半贴壁、悬浮、半悬浮、贴壁与悬浮混合等细胞特性,一般细胞培养PBS量是10%,如果出现细胞状态不良情况,可以提高PBS量到15%,待细胞稳定后,调回PBS量10%,对于初次实验者,一般细胞培养,都需要加入双抗防止细胞污染,细胞汇合度达到90%,我们开始寄送
细胞培养简介:
什么是细胞培养?细胞培养是从动物或植物中取出细胞,然后使其在合适的人工环境中生长。这些细胞可于培养前直接从组织中取出并采用酶或机械方法进行解离,或者也可来自已经建立的细胞系或细胞株。
1)原代培养:
原代培养是指将细胞从组织中分离后,使其在合适的条件下增值直到占据所有可用基质(即:达到汇合状态)的培养阶段。在此阶段。必须将细胞转移到新的容器中并更换新鲜培养基,从而对细胞进行传代培养,为其提供更多继续生长的空间。
2)细胞系:
首次传代培养后,原代培养物即被称为细胞系或者亚克隆。来自于原代培养的细胞系寿命有限(即:有限细胞系,见下文),随细胞的传代,生长能力最强的细胞会占据优势,最终导致细胞群体在基因型和表型上达到一定程度的均一性。
3)细胞株:
如果将细胞系的一个亚群通过克隆或者其他方法从培养物中明确地选择出来,则次细胞系就成为一个细胞株。与亲代细胞系起始时相比,细胞株往往会获得其他一些遗传学改变。
HBL-100;乳腺细胞培养基的选择和使用:
MEM:成分简单,推荐贴壁细胞使用。
DMEM:分高糖型和低糖型。
IDMEM:适合细胞密度低,生长困难的细胞。如杂交细胞的筛选,DNA转染后转化细胞的筛选培养。
RPM1640:应用最广泛的培养基之一。推荐悬浮细胞培养使用,主要针对淋巴细胞,也适合其他细胞。
199、109培养基:成分齐全,培养效果较好。
F10培养基:适合小鼠及人类二倍体细胞培养。
F12培养基:适合单细胞分离培养及无血清培养。
McCoy’s5A培养基:特别适合原代细胞及较难培养细胞的生长。"95%(Viability by Trypan Blue Exclusion)
产品图片:
【细胞检测】:细胞不含有HIV-1、HBV、HCV、支原体、细菌、酵母和真菌
【培养条件】:详见细胞说明书
【传代方法】:建议1:2-1:3 两天换液一次
【冻存条件】:详见细胞说明书
【主要文献】:请具体查阅相关发表文章
造成实验室细胞污染常见情况总结:
细胞培养中最常见污染的是细菌、真菌和支原体污染。细胞一旦污染,大多数较难处理。那么,哪些情况我们不注意的话就会造成细胞污染呢?我们根据常见细胞培养实验分析总结下。
违规操作:1. 为节省时间,有人已经用超净台四个多小时,不开紫外灭菌30min,酒精擦拭后直接开始试验。2. 器材或者溶液很久没用,未检测是否污染而直接使用;离心管多次使用,枪头为了方便交叉使用。3. 超净台不点酒精灯;点了酒精灯放在右上角,而你在左下角做试验。4. 不带手套,徒手操作。5. 细胞培养间配备枪式移液器、手术器械、离心机、冰箱等专用仪器设备以及专用的实验服和拖鞋,未定期消毒。
HBL-100;乳腺细胞专用物品被带出细胞房使用。培养细胞过程中使用的所有实验用具,如移液管、一次性枪头、一次性塑料离心管、冻存管等未按要求灭菌使用(通常需121°C高压灭菌20分钟后37%烤干备用)。
1,超净台和桌面,东西太多太乱
2,箱太久没清洁
3,细胞房人多口杂,难管理:
希望这些培养的方法可以帮到您
HBL-100;乳腺细胞(相关产品):
| BEL-7405 | 肝癌 |
| MEG-01 | 成巨核细胞白血病 |
| HepG2 | 肝细胞癌 |
| L129 | NCTC克隆929 |
| L-M TK | 鼠胸腺激酶缺陷细胞株 |
| STO | 鼠胚成纤维细胞系 |
| YAC-1 | 鼠T淋巴瘤细胞系 |
| MA-782 | 鼠乳腺癌细胞系 |
| GR | 鼠成纤维细胞系 |
| NIH/3T3 | 鼠成纤维细胞系 |
| B16-Fo | 鼠黑色素瘤细胞系 |
| B16-F1 | 鼠黑色素瘤细胞系 |
| PC-12 | 鼠肾上腺嗜铬细胞瘤细胞系 |
| H22 | BALB/C小鼠肝癌细胞系 |
| BHK-21 | 叙利亚仓鼠肾细胞系 |
| CHO-K1 | 中国仓鼠卵巢细胞系 |
| P3/NS1/1-Ag4-1 | 鼠骨髓瘤细胞 |
| SP2/0-Ag14 | 鼠骨髓瘤细胞 |
| P3X63-Ag8.653 | 鼠骨髓瘤细胞 |
| B6YH4 | 杂交瘤细胞(B6YH4)枝原体阳性 |
| B82 | 鼠细胞系 |
| CoC1 | 人卵巢癌细胞系 |
| CoC1/DDP | CoC1细胞耐药亚株 |
| Hep-2 | 人喉癌细胞系 |
| KMB-17 | 人二倍体细胞系 |
| WI-38 | 人二倍体细胞系 |
风险提示:丁香通仅作为第三方平台,为商家信息发布提供平台空间。用户咨询产品时请注意保护个人信息及财产安全,合理判断,谨慎选购商品,商家和用户对交易行为负责。对于医疗器械类产品,请先查证核实企业经营资质和医疗器械产品注册证情况。
技术资料暂无技术资料 索取技术资料
HBL-100;乳腺细胞
¥600 - 2000